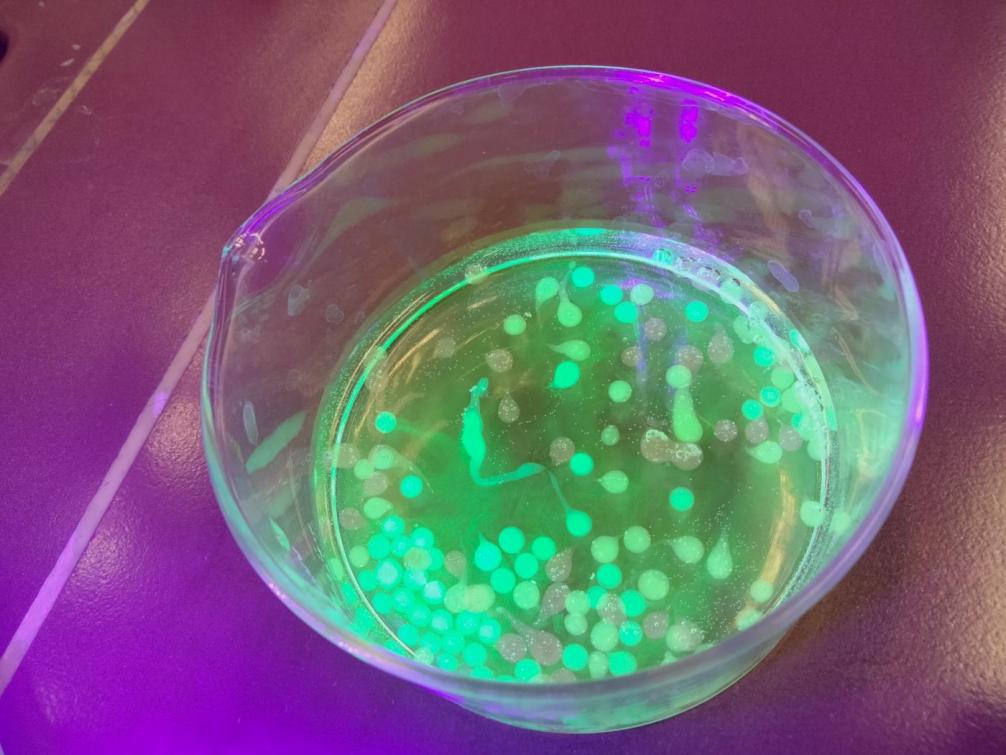
MINT-Lab 2025 (Klasse 2)

Auf Entdeckungsreise im MINT-Lab Perjen
Diesen Mittwoch ging es mit unserer zweiten Klasse zum MINT-LAB in Perjen.
Die Kinder entdeckten die Bereiche Mathematik, Informatik, Naturwissenschaften und Technik (MINT) aus einem völlig neuen Blickwinkel.
Besucht wurden die Workshops:
🔹Lego einmal anders – bauen, tüfteln und kreativ denken
🔹Fluoreszenz – die Welt der leuchtenden Farben entdecken
🔹 Steinzeit trifft Hightech – wenn Vergangenheit auf moderne Technik trifft
Die teils futuristisch wirkenden Welten waren plötzlich ganz nah. Forschen, Tüfteln, Werkeln und Ausprobieren lautete das Motto der Workshops.
Wir danken den Verantwortlichen von MINT Oberland und dem Gymnasium Perjen für einen hochinteressanten und rundum inspirierenden Vormittag!